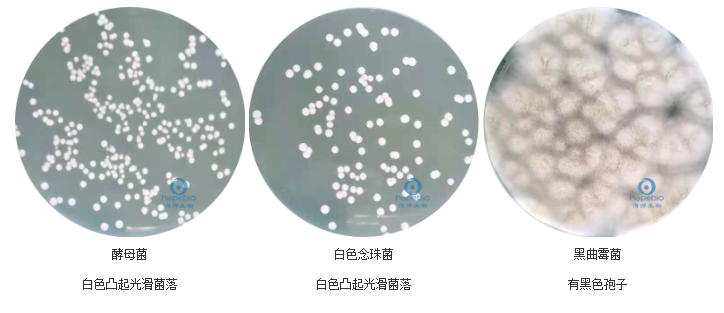
19204184.png

HBPM5193 酵母浸出粉胨葡萄糖琼脂(YPD)平板
发布时间 :2025-05-22 发布人:yumiaoshengwu 浏览量:递增失败!
基本信息
产品名称:酵母浸出粉胨葡萄糖琼脂(YPD)平板
产品货号:HBPM5193
生产厂家:青岛海博
包装规格:90mm x 10 个 / 包
产品用途:用于测定酵母菌总数。
保存温度:2-8℃避光保存
保质期:三个月
成分组成
产品特性
外观:平板培养基应为淡黄色,表面平整、均匀,无不溶物。
pH 值:pH6.0±0.2(25℃)。
无菌性:经过低剂量辐照灭菌,采用三层包装,确保无菌,防止琼脂受污染和降解。
凝胶强度:强度在 450-600g/cm²,能保持培养基的固体形态,便于操作和微生物生长。
检验原理:胨提供碳源和氮源;酵母浸出粉提供B族维生素能促进生长;葡萄糖提供能源;琼脂是培养基的凝固剂。
注意事项:本品仅限于实验室检测使用,不得用于其他用途;使用时应严格遵守无菌操作规范,避免杂菌污染,影响检测结果;若培养基出现过期、变色、干裂等情况,请勿使用。
不同细菌在酵母浸出粉胨葡萄糖琼脂(YPD)平板上生长特征: